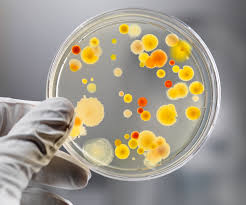
ಬದುಕನ್ನು ಬದಲಿಸುವ ಸೂಕ್ಷ್ಮಜೀವಿಗಳು !

ARCHIVE SiteMap 2020-04-17
 ಗುವಾಂಗ್ಝೂನಲ್ಲಿ ತಲೆಎತ್ತಲಿದೆ ಬೃಹತ್ ಫುಟ್ಬಾಲ್ ಸ್ಟೇಡಿಯಂ
ಗುವಾಂಗ್ಝೂನಲ್ಲಿ ತಲೆಎತ್ತಲಿದೆ ಬೃಹತ್ ಫುಟ್ಬಾಲ್ ಸ್ಟೇಡಿಯಂ ಶರತ್ ಕಮಲ್ ಭಾರತದ ಗರಿಷ್ಠ ರ್ಯಾಂಕಿನ ಆಟಗಾರ
ಶರತ್ ಕಮಲ್ ಭಾರತದ ಗರಿಷ್ಠ ರ್ಯಾಂಕಿನ ಆಟಗಾರ ಇಂದಿನಿಂದ ಎಸ್ಸೆಸ್ಸೆಫ್ ವತಿಯಿಂದ ಕ್ಯಾಂಪಸ್ ವಿದ್ಯಾರ್ಥಿಗಳಿಗೆ ವಿವಿಧ ಸ್ಪರ್ಧೆಗಳು
ಇಂದಿನಿಂದ ಎಸ್ಸೆಸ್ಸೆಫ್ ವತಿಯಿಂದ ಕ್ಯಾಂಪಸ್ ವಿದ್ಯಾರ್ಥಿಗಳಿಗೆ ವಿವಿಧ ಸ್ಪರ್ಧೆಗಳು ದುಡಿಮೆಯಿಲ್ಲದೆ ಸಂಕಷ್ಟಕ್ಕೀಡಾದ ಆಟೊ ಚಾಲಕರು
ದುಡಿಮೆಯಿಲ್ಲದೆ ಸಂಕಷ್ಟಕ್ಕೀಡಾದ ಆಟೊ ಚಾಲಕರು ಬದುಕನ್ನು ಬದಲಿಸುವ ಸೂಕ್ಷ್ಮಜೀವಿಗಳು !
ಬದುಕನ್ನು ಬದಲಿಸುವ ಸೂಕ್ಷ್ಮಜೀವಿಗಳು ! ಲಾಕ್ಡೌನ್ ನಡುವೆಯೂ ಅಂಚೆ ಮುಖಾಂತರ ಮನೆಬಾಗಿಲಿಗೆ ಮಾವು!
ಲಾಕ್ಡೌನ್ ನಡುವೆಯೂ ಅಂಚೆ ಮುಖಾಂತರ ಮನೆಬಾಗಿಲಿಗೆ ಮಾವು! ಅಮೆರಿಕದಲ್ಲಿ 24 ಗಂಟೆಯಲ್ಲಿ ಕೋವಿಡ್-19ಕ್ಕೆ ಬಲಿಯಾದವರ ಸಂಖ್ಯೆ 4,491ಕ್ಕೇರಿಕೆ
ಅಮೆರಿಕದಲ್ಲಿ 24 ಗಂಟೆಯಲ್ಲಿ ಕೋವಿಡ್-19ಕ್ಕೆ ಬಲಿಯಾದವರ ಸಂಖ್ಯೆ 4,491ಕ್ಕೇರಿಕೆ ಲಾಕ್ಡೌನ್: ತಲೆ ಎತ್ತಿದ ತರಕಾರಿ ಕಳ್ಳರ ಜಾಲ!
ಲಾಕ್ಡೌನ್: ತಲೆ ಎತ್ತಿದ ತರಕಾರಿ ಕಳ್ಳರ ಜಾಲ! ಮಂಗಳೂರು: ಪೊಲೀಸರ ಕರ್ತವ್ಯಕ್ಕೆ ಅಡ್ಡಿ, ನಿಂದನೆ; ಸುರೇಶ್ ರಾವ್ ವಿರುದ್ಧ ಪ್ರಕರಣ ದಾಖಲು
ಮಂಗಳೂರು: ಪೊಲೀಸರ ಕರ್ತವ್ಯಕ್ಕೆ ಅಡ್ಡಿ, ನಿಂದನೆ; ಸುರೇಶ್ ರಾವ್ ವಿರುದ್ಧ ಪ್ರಕರಣ ದಾಖಲು ಲಾಕ್ಡೌನ್ನ ದುರ್ಬಳಕೆಯಾಗದಿರಲಿ
ಲಾಕ್ಡೌನ್ನ ದುರ್ಬಳಕೆಯಾಗದಿರಲಿ ಒಂದೇ ದಿನ ನಾಲ್ಕು ಕಡೆ ಆರೋಗ್ಯ ಕಾರ್ಯಕರ್ತರ ಮೇಲೆ ಹಲ್ಲೆ
ಒಂದೇ ದಿನ ನಾಲ್ಕು ಕಡೆ ಆರೋಗ್ಯ ಕಾರ್ಯಕರ್ತರ ಮೇಲೆ ಹಲ್ಲೆ ಮಧ್ಯಪ್ರದೇಶದಲ್ಲಿ ಒಂದೇ ದಿನ 361 ಹೊಸ ಕೋವಿಡ್-19 ಪ್ರಕರಣ ಪತ್ತೆ
ಮಧ್ಯಪ್ರದೇಶದಲ್ಲಿ ಒಂದೇ ದಿನ 361 ಹೊಸ ಕೋವಿಡ್-19 ಪ್ರಕರಣ ಪತ್ತೆ